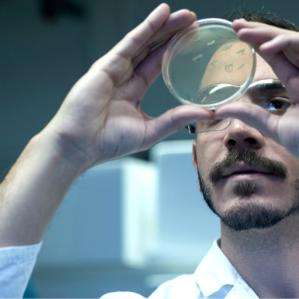

WHERE EXPERTISE MEETS GLOBAL REACH
We understand the unique logistical challenges that the healthcare industry faces. That’s why we design our solutions to be flexible, timely, and
cost-effective.
With over 120 specialised sites in more than 40 countries and a dedicated team of 8,000 healthcare professionals, we can promise unparalleled
global capability and expertise. This gives your supply chains the resilience to adapt swiftly and effectively to new market challenges.

Key benefits:
Scalable warehousing:
Adapt to market demands with our
flexible facilities.
Temperature-controlled
distribution:
Transport in any condition, from
deep frozen to chilled to ambient.
Quality assurance:
Maintain compliance with
industry standards for facilities
and processes.
Global reach:
Get your products where they need
to be, safely and quickly, while
preserving quality control.
Real-time monitoring:
Keep track of your goods every
step of the way.
Read more on how DHL deliver next-level healthcare in our new whitepaper.
SPECIALIST LIFE SCIENCES & HEALTHCARE SERVICES
PHARMACEUTICAL
Navigating the complex world of pharmaceutical logistics requires a partner who can adapt to its ever-changing demands. From seasonal supply challenges to pandemic planning, we provide disciplined temperature control procedures to protect your high-value products, while maintaining efficiency and compliance.

MEDICAL DEVICES
Whether you’re manufacturing bespoke surgical implants or mass-produced diagnostic machines, each product comes with its unique set of challenges. Our warehousing and distribution services are designed to offer the flexibility, efficiency, and expertise you need, empowering you to carry out everything from product testing to shipment.

HOSPITAL AND
HEALTHCARE SERVICES
We don’t just move goods, we enhance the experience for both our Customers and, in turn, patients. Our specialised logistics and fleet management solutions are designed to improve the operational efficiency of hospitals and healthcare groups, reducing congestion, optimising space, and maintaining the right inventory levels.
CONNECTING PEOPLE, IMPROVING LIVES
Curious about how we’re transforming healthcare logistics? This video explores how our sector expertise, digitalisation, and compliance infrastructure are driving supply chain resilience across the UK and Ireland. Discover how DHL is empowering healthcare networks, and ultimately helping to save lives.
LEARN MORE ABOUT OUR LIFE SCIENCES & HEALTHCARE EXPERTISE
Discover how we bring Healthcare to the world through these insights.
CONTACT OUR EXPERTS
When you partner with DHL Supply Chain, our leading Life Sciences & Healthcare logistics experts become an extension of your own team that you can rely on. Provide your details using the form below to connect with one of our experts today and discover how we can help you achieve success.








